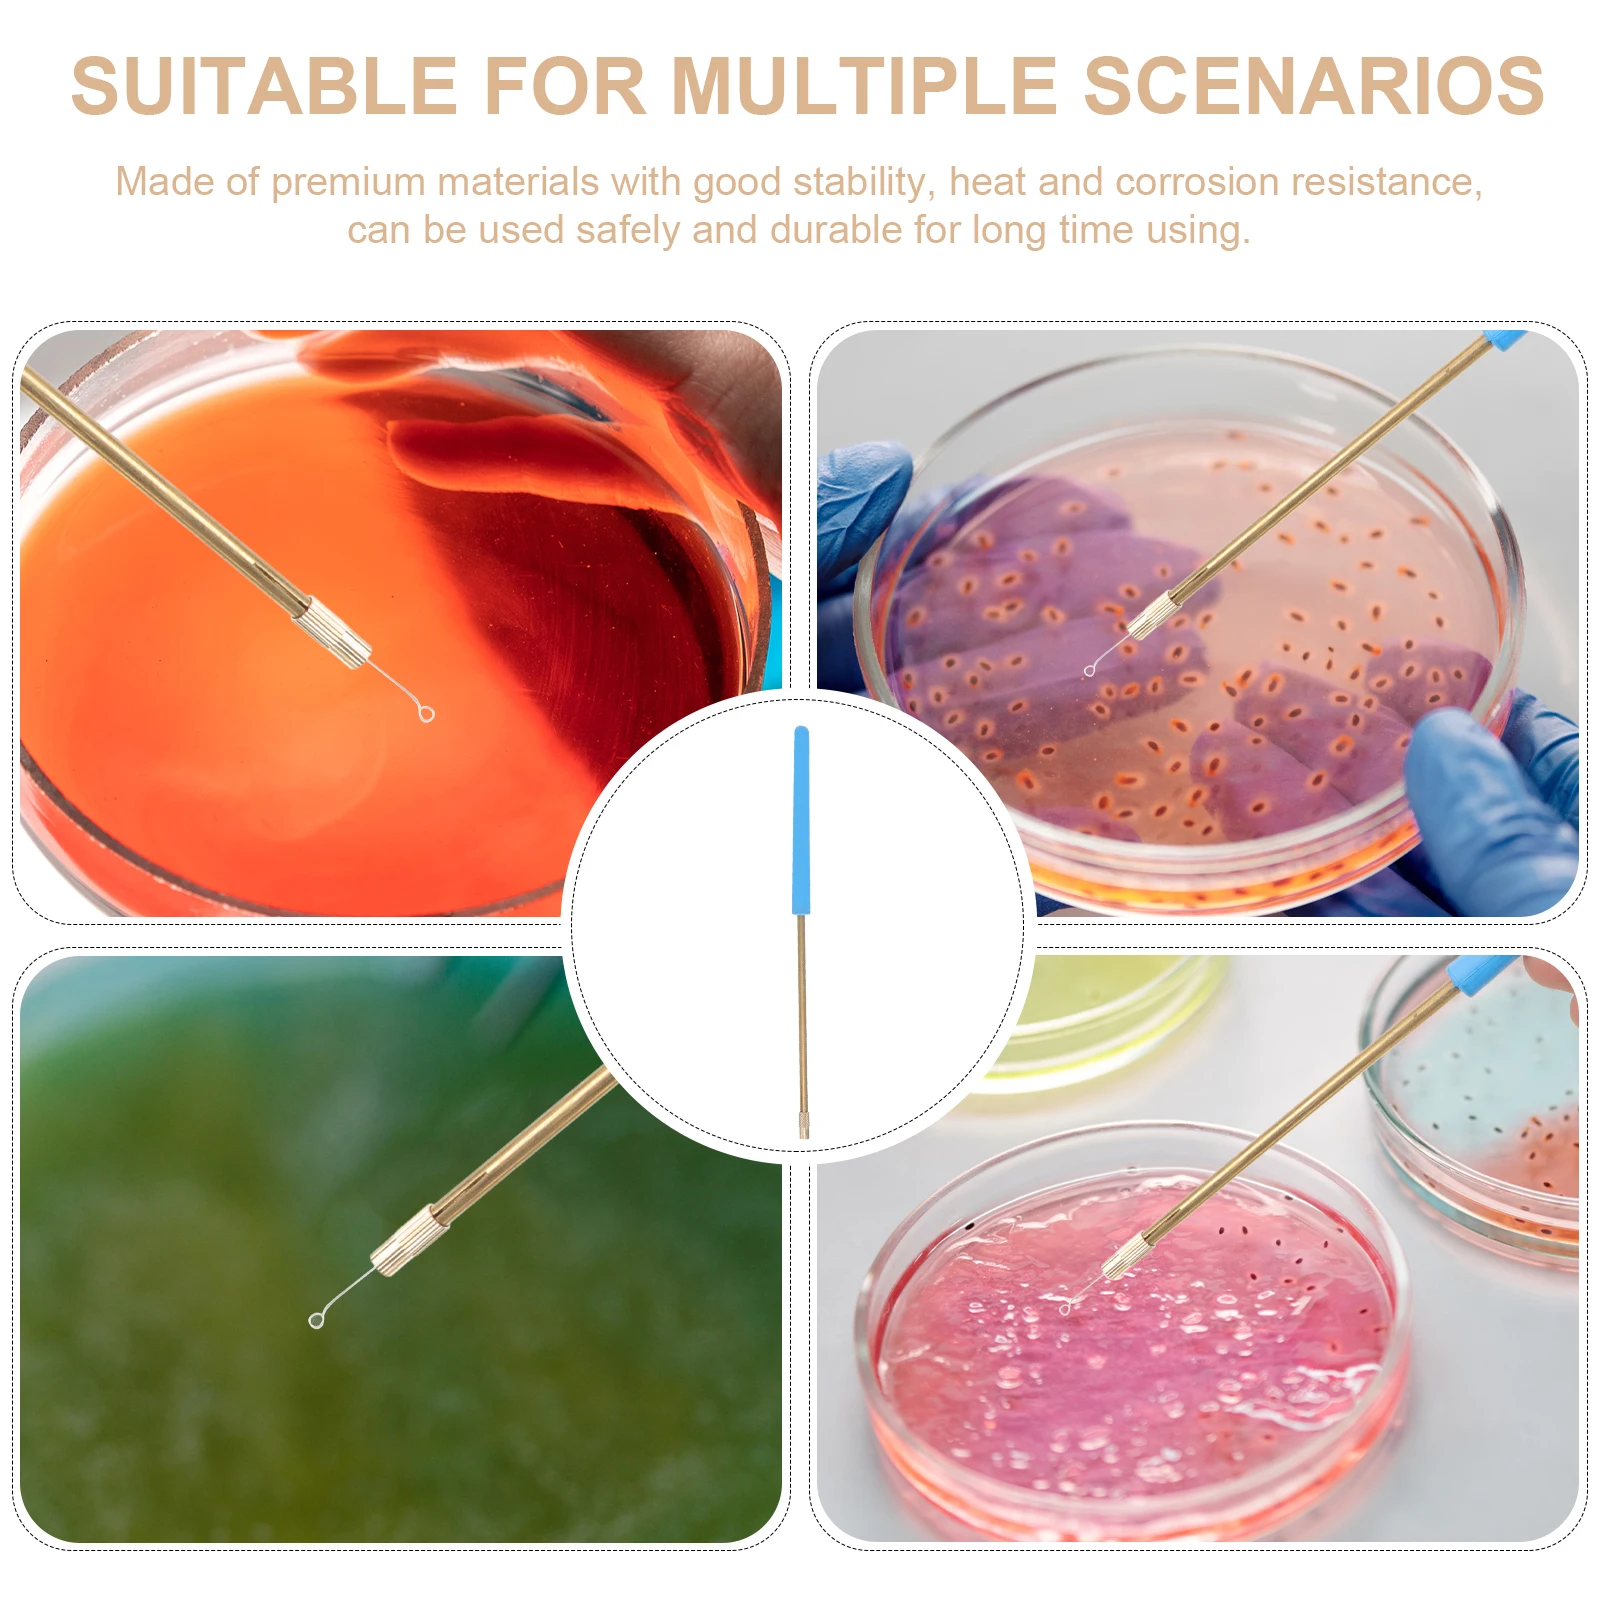
thumb

1 Set Microbiology Inoculation Rod Copper Rings Reusable Lab Tools For Science Laboratory Classroom Lightweight Compact
Price history chart & currency exchange rate
Customers also viewed

$99.58
Forward X Tactical Pants Autumn And Winter High-Quality Camouflage Pants Men's Outdoor Clothing
aliexpress.com
$103.64
Подходит для Kawasaki ZX-6R 636 2009-2016 Φ 08-09 заднее крыло корпус заднего номерного знака сигнала поворота, защитный номерной знак
aliexpress.com
$7.05
FC to FC UPC 3M Fiber Optical Patch Cable Singlemode Simplex 3.0mm Bend Insensitive Fiber Optic Cord
aliexpress.com
$18.75
TRAF 2024 Gold Metallic Sweaters for Women Pullover Knitted Sweater Woman Long Sleeve Women's Sweaters Shoulder Pads Knitwears
aliexpress.ru
$17.04
2023Tee Shirt Homme Personalized Jacquard Hot Drill Slim Fit Elastic Ice Silk Short Sleeve T-shirt Round Neck Sweater Men Tshirt
aliexpress.com
$5.36
6/8 мм естественная планета Будда, медитация, дерево, молитва, женский и мужской браслет, ювелирные изделия 108 планшетов
aliexpress.ru
$22.99
Men's Collar Polo Shirt Golf Shirt Geometry Turndown Blue Pink Yellow Light Green Light Brown 3D Print Outdoor Street Short Sleeves Zipper Print Clothing Apparel Fashion Designer Casual Breathable
lightinthebox.com
$1.01
Disney Hawaiian Girl Lilo And An Outer Space Creature Stitch Play Animation Brooch Acrylic Brooch Gift Cartoon Jewelry
aliexpress.com
$70.59
men's down parkas 5xl men winter new casual classic warm thick fleece parkas jacket coat men autumn fashion pockets windproof parka men, Black
dhgate.com
$17.96
women's t-shirt aiithuug miidriff long sleeve yoga sports fitness crop gym shirts slim fit running tank criss cross waist cross 23082, White
dhgate.com
$150.90
mc luxury handbag fashion women genuine leather ladies shopping classical girl's 3w9b
dhgate.com
$41.99
A-Line Floor Length Crew Neck Chiffon Junior Bridesmaid Dresses&Gowns With Pleats Wedding Party Dresses 4-16 Year
lightinthebox.com
$26.31
Short Curly Bob Pixie Cut Full Machine Made No Lace Human Hair Wigs With Bang For Black Women Remy Brazilian Hair
lightinthebox.com
$22.18
Women's Pajamas Sets Pjs 2 Pieces Grid / Plaid Comfort Home Daily Cotton Long Sleeve Winter Fall Black
lightinthebox.com
$120.00
100 шт./лот 50 мл стеклянная бутылка для лосьона, пустая косметическая бутылка для сыворотки лица с дозатором в упаковке
aliexpress.ru
$47.01
Firefly Q7 120° Wide Angle Wifi Mini Camera 1080P FPV Action Camera With Bracket 0.66Inch OLED Display For FPV Racing Drone
aliexpress.com
$11.20
Kitchen timer stainless steel cooking eggs 60 minutes mechanical alarm clock baking cooking tools countdown time management
aliexpress.com
$0.73
20 штук, S-vormige haak стойка, мини-многофункциональное устройство, S-образное вытянутое Рождественское украшение, Декор, стебель haak
aliexpress.com
$1.21
2 Pin D-Shape Earpiece Headset MIC PTT Mic Earpiece Earphone for Baofeng for Kenwood for Puxing TYT Radio
aliexpress.com
$10.25
Compact Smokeless Ashtray Detachable Car Cigarette Ashtray with LED Light USB Rechargeable Car Trash Can for Travel Home
aliexpress.com
$11.38
Настольная карманная диаграмма, двусторонняя и Самостоятельная карманная мини-карточная подставка для отдельных или небольших групп (43X 33 ...
aliexpress.com
$8.33
Electric Men's Shaver Razor Barber 3D Floating Reciprocating Beard Hair Trimmer Mini Rechargeable Travel Face Care Safe Razor 45
aliexpress.com
$61.96
NEW-Car HUD Head Up Display for Mazda CX-4 2018 2019 Safe Driving Sn OBD Speeeter Projector
aliexpress.com
$2.79
10Pcs Wormwood Health Detox Foot Patch Effective Improve Sleep Quality Cleansing E65F
aliexpress.com
$5.42
3D Window Stickers Static Electricity Glass Film Glue-free Technology Repeat Tearing No Trace Privacy Adhesive for Home Decor
aliexpress.com
$42.92
v-coool insulated baby bottle bag maternity feeding milk fresh keeping storage nursing diaper bags thermal backpack dco
dhgate.com
$11.44
Solid color zipper cardigan Hooded couple fashion hoodies Casual Youth Street Hip Hop High Street Sweatshirt Spring fall coat
aliexpress.com
$74.13
fashion summer high mens shoes genuine cow leather hip hop ankle shoes mixed colors flats motorcycle boots men plus size
dhgate.com
$32.97
дизайнер женщин купальники один кусок купальники спинки дизайнер бренд бикини монокини straped купальники для леди бесплатная корабль джей-д, White;black
dhgate.com
$15.68
OKH Personality Thick Frame Myopia Glasses European and American Women Men Anti-blue Light Frame Prescription Eyeglasses Reading
aliexpress.com
$6.40
Набор из 6 массажеров для головы и кожи головы в форме осьминога, многофункциональный стальной массажный инструмент для шеи, плеч, ног, снятия стресса, ручной массажер для расслабления
aliexpress.ru
$1.28
Для повседневной носки, дышащее бесшовное мужское нижнее белье, повседневная прогулка, фиолетовый, 10 спандекс, 90, полиэстер, бесшовный дизайн
aliexpress.ru
$26.27
Пуловеры длиной до колена для студентов, свитера, джемперы, женские элегантные ребристые лоскутные праздничные взрослые, Moricore, эластичные полосатые модели
aliexpress.ru